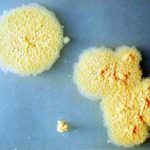
Un batterio rende più intelligenti e tranquilli

L’agave: probiotico vegetale per la salute dell’intestino

1 Giugno 2010
L’agave agisce come probiotico vegetale, in grado di far aumentare nettamente il numero di bifidobatteri e lattobacilli nel corpo umano.
Lo afferma una ricerca della National Autonomous University of Mexico e della Università di Reading, diretta dalla dottoressa Adele Costabile e pubblicata su “Journal of Applied
Microbiology”.
La squadra della dottoressa Costabile ha preso in esame l’inulina: un polisaccaride che si trova in diverse piante, composto da fibra solubile. Secondo gli esperti, l’inulina facilita la
digestione e riduce il gas intestinale, facendo aumentare i batteri buoni (bifidobatteri) e diminuendo quelli nocivi. Per questo, è inserita in numerosi prodotti a base di fermenti
lattici.
Allora, i ricercatori ipotizzano come l’agave possa essere agire come alternativa a tale polisaccaride.
Per provarlo hanno compiuto esperimenti in vitro, mettendo a confronto un estratto d’agave con 4 probiotici, tra cui la cellulosa. L’osservazione ha evidenziato “La potenzialità
attività prebiotica dei fruttani di Agave che mostrano un significativo aumento delle popolazioni di lattobacilli e bifidobatteri, rispetto alla cellulosa utilizzata come controllo”.
Tali buoni risultati dovranno essere confermati; tuttavia, gli scienziati sostengono che l’inulina derivata dall’agave ha un potenziale effetto prebiotico in quanto ha fatto aumentare la
crescita di bifido batteri e lattobacilli.
Tale effetto, concludono la dottoressa Costabile e colleghi, “E’ simile a quello osservato nel caso dell’inulina contenuta nei prebiotici derivati dalla radice di cicoria, giustificando
così il potenziale dell’Agave come prebiotico
Fonte: E. Gomez, K.M. Tuohy, G.R. Gibson, A. Klinder, A. Costabile, “In vitro evaluation of the fermentation properties and potential prebiotic activity of Agave fructans”,
Journal of Applied Microbiology 2010
Matteo Clerici
ATTENZIONE: l’articolo qui riportato è frutto di ricerca ed elaborazione di notizie pubblicate sul web e/o pervenute. L’autore, la redazione e la proprietà, non
necessariamente avallano il pensiero e la validità di quanto pubblicato. Declinando ogni responsabilità su quanto riportato, invitano il lettore a una verifica, presso le fonti
accreditate e/o aventi titolo.